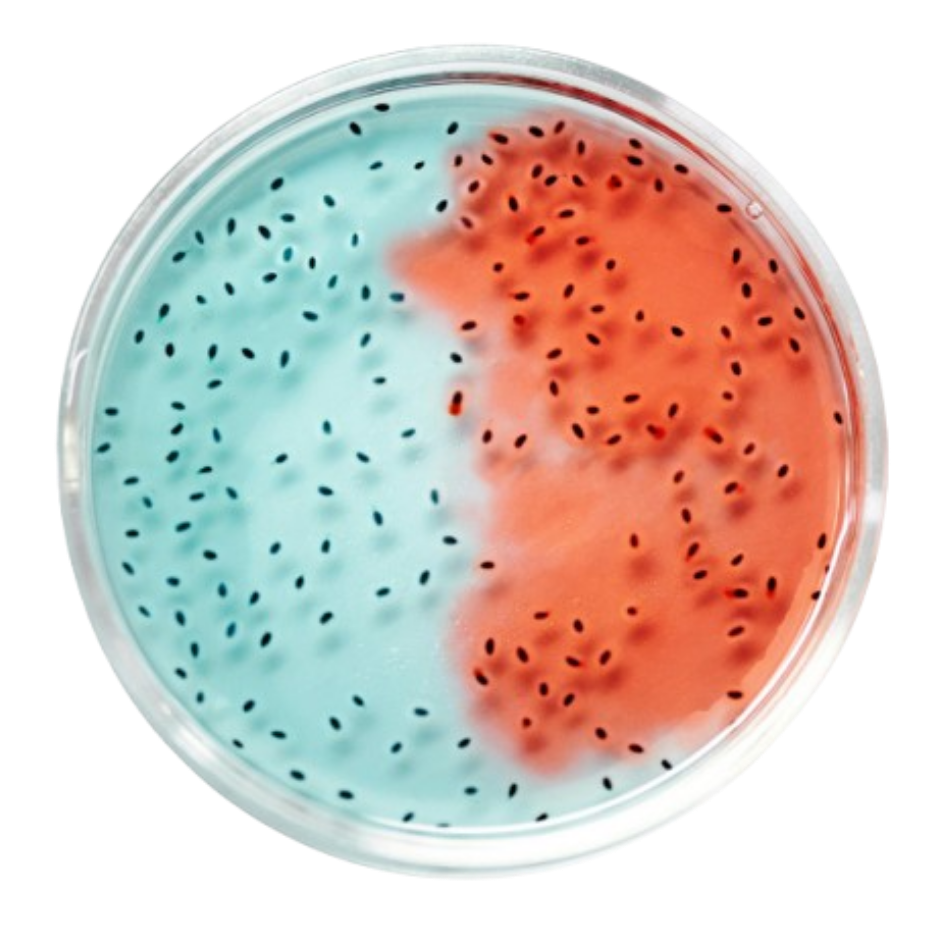
0.5% Climbazole
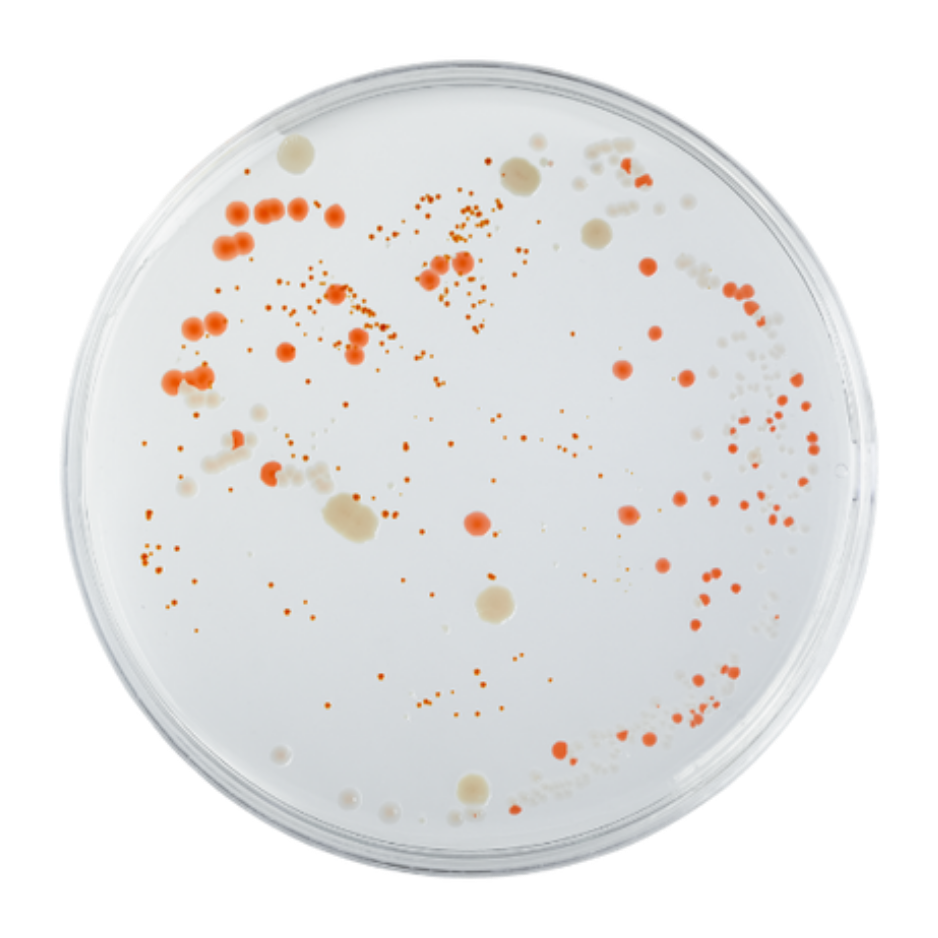
1% Salicylic Acid

Custumising your plan...
- Analysing your responses
- Making Changes iin your kit
- Building yout next month kit
.png)
Haven’t account? sign up
India's Most Researched & Clinically Proven

Scientifically-formulated ingredients that work synergistically for optimal hair health and growth.

Awakens dormant hair cells to generate new growth phases.
Organic pea sprout extract, stimulates hair growth & increases hair volume.
Boosts hair growth & thickness by revitalising hair follicles.

Derived from olive leaves & citrus peels, to fight premature hair loss.

Strengthens hair & minimises hair loss.

Penetrates deep into the scalp, maximizing the impact of hair growth actives.
Follow these simple steps to get the most out of your experience.
Use 2 pumps on wet scalp
Gently massage and let it foam for 5–7 mins
Wash thoroughly, use a conditioner after usage.
Use 3 times a week, alternately


Shop our expertly formulated shampoos designed to target your every hair & lifestyle need by nourishing, strengthening and repairing hair including options like sulfate-free and dry shampoo.
.png)
.png)
At Fidore Health, we combine science-backed formulations with globally recognized safety standards. Our products undergo rigorous testing and clinical validation to ensure you receive only the best in clean, effective wellness solutions. Trusted by experts, loved by customers.

Dermatologically Tested

FDA Approved

Cruelty Free
Here's why customers choose Fidore Health for their hair growth journey — clean ingredients, proven results, and a nourishing experience.

Boosts Hair Growth
Stimulates hair follicles at the root for visible results.

Improves Scalp Health
Nourishes the scalp to create a healthy growth environment.

Reduces Hair Fall
Helps retain existing hair and prevents excessive shedding.

Lightweight & Non-Sticky
Absorbs quickly without leaving residue behind.

Improves Hair Density
Thicker, fuller-looking hair with consistent use.